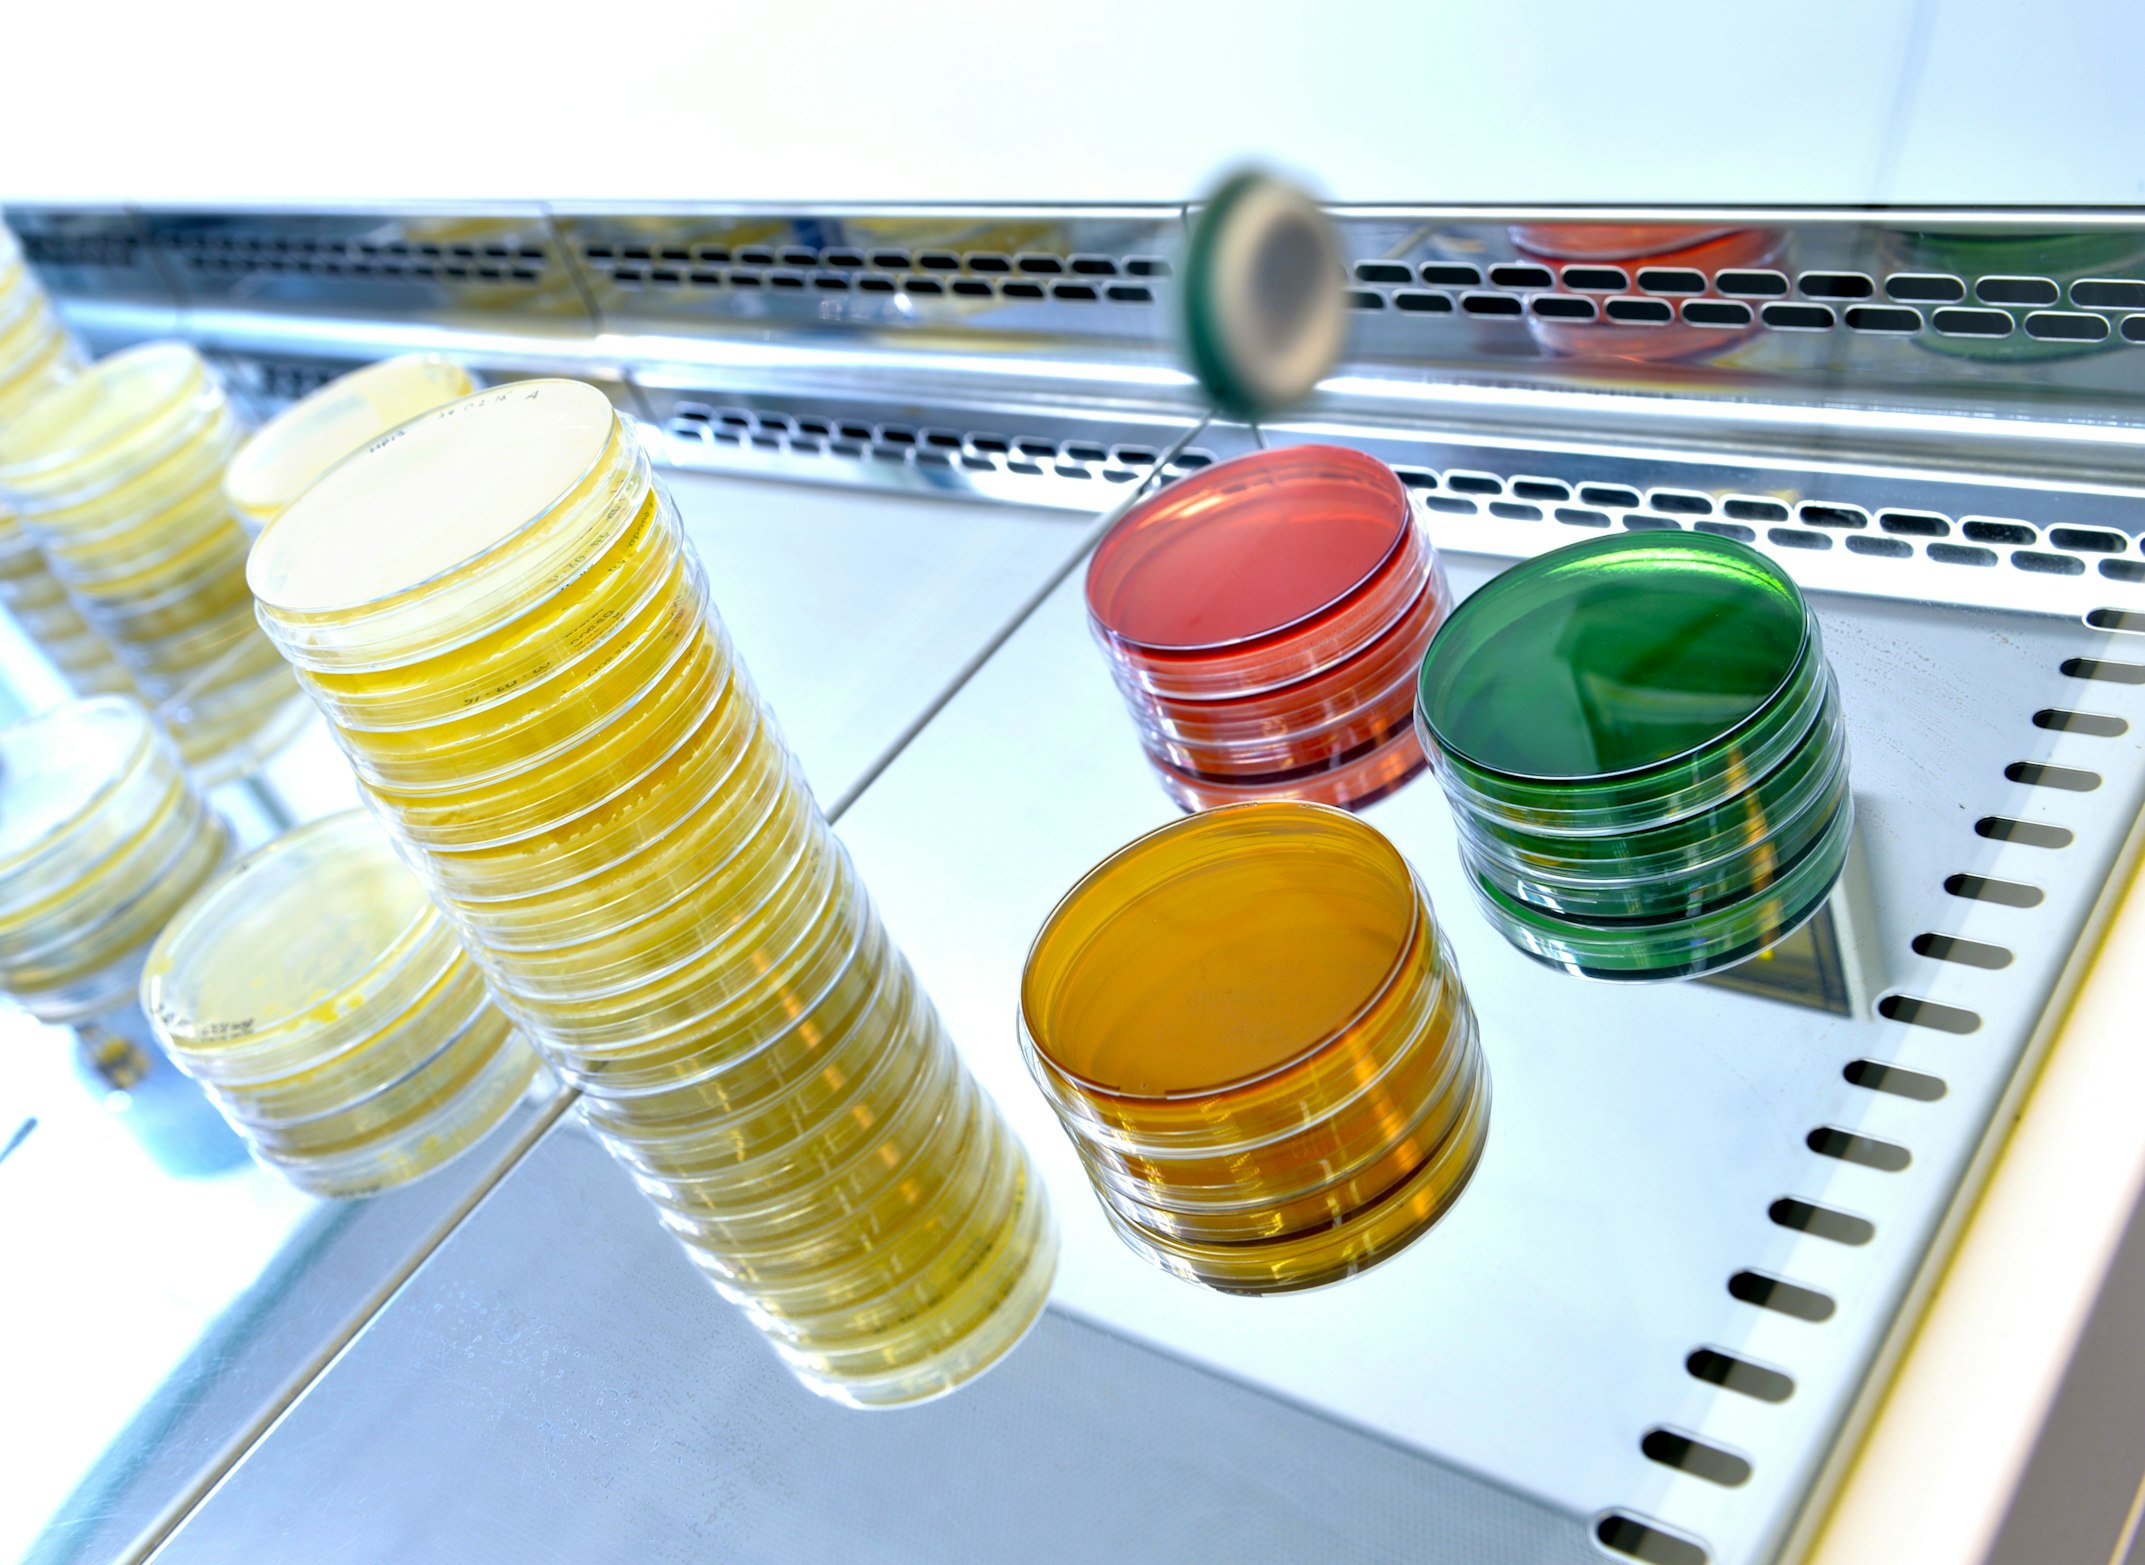

We're committed to
sustainable cleaning practices

Making a difference
Being part of the solution
Since the 1950s, over 70,000 new chemical compounds have been created, with few tested for human toxicity. The commercial cleaning industry also releases over 350,000 litres of harsh chemicals into the environment monthly.
We are proud to be different.
At JK Building Wellness, we recognise the environmental impact of traditional cleaning methods and are dedicated to reducing our footprint.
- Environmental impact
Traditional cleaning products often contain harsh chemicals that contribute to pollution, both indoors and outdoors. From chemical runoff contaminating waterways to plastic packaging filling up landfills, the environmental toll of conventional cleaning methods is undeniable. That's why we are proud to be doing things differently. - Our approach
We're committed to reducing our environmental impact by prioritising eco-friendly cleaning practices and eco-benign probiotic cleaning products. Our team of franchisees use these solutions as they are safe for people and do no harm to the environment. By reducing our reliance on harmful chemicals and using eco-friendly cleaning practices, we are minimising our environmental footprint while still delivering exceptional cleaning results.
By partnering with us, your business is not only ensuring a clean and healthy environment but also contributing to a better future for New Zealand through our dedicated sustainable practices.
The power of probiotic cleaners
These innovative probiotic cleaners are created using advanced chemical technology and combined with specific bacillus cultures. These cultures have the remarkable ability to penetrate deep into surfaces, effectively breaking down stubborn dirt, grime, and odours, providing long-lasting cleaning results without causing harm to the environment.

What Are Probiotic Cleaners?
Our commitment to environmental responsibility is demonstrated through our use of eco-friendly probiotic products to clean our clients' workplaces. These innovative products are created using advanced chemical technology and combined with specific bacillus cultures. These cultures have the remarkable ability to penetrate deep into surfaces, effectively breaking down stubborn dirt, grime, and odours, providing long-lasting cleaning results without causing harm to the environment.
Unlike harsh chemical cleaners that eliminate all bacteria on surfaces, our probiotic cleaning products work differently. They safeguard surfaces by introducing beneficial bacteria that offer enduring cleaning and odour control. Our range of eco-benign probiotic cleaners includes sanitiser, general purpose cleaner, odour neutraliser, and carpet cleaner.

Pioneering industry leadership
Our environmental impact
We strive to make a positive impact on the environment, our people, and the local communities we serve. We are a company committed to sustainability and the health and safety of our team and clients.
- Toitū Enviromark Diamond certification
Our commitment to conducting business sustainably has been certified by Toitū Enviromark® Diamond level, which means our environmental management system has been independently verified. Toitū enviromark programme requirements meet and exceed international standards and best practices, including ISO 14001. - Trees That Count
We're thrilled to be helping Aotearoa, New Zealand, to restore our natural environment by donating trees on behalf of our clients.
We partner with Trees That Count and gift a native New Zealand tree to each new client. We are proud to be making a difference in our big backyard, together. All trees are planted and cared for by communities across NZ.
Sustainable cleaning practices for a better tomorrow
It has never been more important for New Zealand businesses to act against climate change and operate sustainably in everything they do. That's why we consider it in every aspect of our business.
Our goals, initiatives and measures will align with and contribute to the United Nations Sustainability Development Goals (UNSDGs). The result will be: we are doing good business, by doing good for the planet and its people.
Find out more: Sustainability Booklet
We are proudly part of the NZervio Group of companies – a Sustainable Property Services Group who are committed to developing impactful and sustainable business practices.
- Culture
We are a values-based, purposeful business that seeks to change lives and ensure healthy buildings for families and businesses. - Planet & the environment
Transport emissions are the fastest-growing source of greenhouse gas emissions in the country. Supported by the Toitū Carbon Compatible programme, we are collecting and measuring our emissions, with the goal of 50% emission reduction by 2030. - Community
'Changing people’s lives, one business at a time' is a core driver behind our business. We foster social benefit through partnerships with franchisees, staff and local communities, and focus on personal and professional growth. - Modern slavery & human rights
We are committed to integrity and fairness in how we relate to each other, our customers, franchisees and business partners. - Responsible consumption, waste & efficiency of operations
Operational efficiency underscores our business practices and we recognise the importance of minimising the environmental footprint. - Innovations & improvements
Continuous evaluation supports our commitment to sustainable business operation, a safe workplace and a healthy environment.